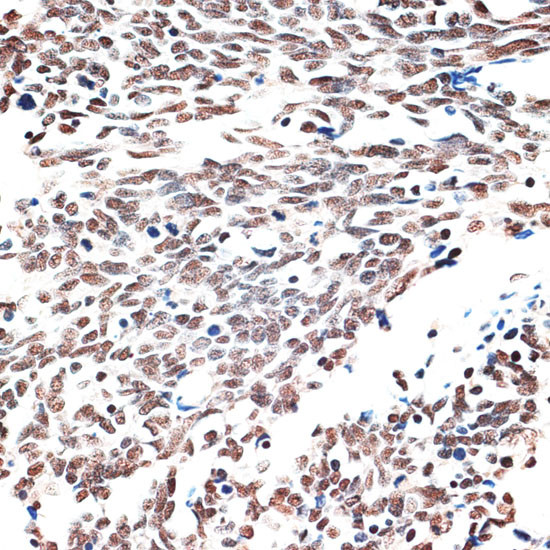
AQR Antibody in Immunohistochemistry (Paraffin) (IHC (P))

Search
Invitrogen
AQR Polyclonal Antibody
{{$productOrderCtrl.translations['antibody.pdp.commerceCard.promotion.promotions']}}
{{$productOrderCtrl.translations['antibody.pdp.commerceCard.promotion.viewpromo']}}
{{$productOrderCtrl.translations['antibody.pdp.commerceCard.promotion.promocode']}}: {{promo.promoCode}} {{promo.promoTitle}} {{promo.promoDescription}}. {{$productOrderCtrl.translations['antibody.pdp.commerceCard.promotion.learnmore']}}
图: 1 / 4
AQR Antibody (PA5-109403) in IHC (P)




Please note: We are reviewing Western blot images included in the antibody testing data in our catalog, including those provided by third parties. Unless expressly labeled or annotated as “raw-unedited”, Western blot images included in the antibody testing data in our catalog may have been edited, optimized or otherwise adjusted for presentation.
产品信息
PA5-109403
种属反应
宿主/亚型
分类
类型
抗原
偶联物
形式
浓度
规格
纯化类型
保存液
内含物
保存条件
运输条件
RRID
产品详细信息
Immunogen sequence: KEFLLELLVS RHERRISQIQ QLNQMPLYPT EKIIWDENIV PTEYYSGEGC LALPKLNLQF LTLHDYLLRN FNLFRLESTY EIRQDIEDSV SRMKPWQSEY GGVVFGGWAR MAQPIVAFTV VEVAKPNIGE NWPTRVRADV TINLNVRDHI KDEWEGLRKH DVCFLITVRP TKPYGTKFDR RRPFIEQVGL VYVRGCEIQG MLDDKGRVIE DGPEPRPNLR GESRTFRVFL DPNQYQQDMT NTIQNGAEDV YETFNIIMRR KPKENNFKAV LETIRNLMNT DCVVPDWLHD IILGYGDPSS A
靶标信息
Involved in pre-mRNA splicing as component of the spliceosome (PubMed:11991638, PubMed:25599396, PubMed:28502770, PubMed:28076346). Intron-binding spliceosomal protein required to link pre-mRNA splicing and snoRNP (small nucleolar ribonucleoprotein) biogenesis (PubMed:16949364). Plays a key role in position-dependent assembly of intron-encoded box C/D small snoRNP, splicing being required for snoRNP assembly (PubMed:16949364). May act by helping the folding of the snoRNA sequence. Binds to intron of pre-mRNAs in a sequence-independent manner, contacting the region between snoRNA and the branchpoint of introns (40 nucleotides upstream of the branchpoint) during the late stages of splicing (PubMed:16949364). Has ATP-dependent RNA helicase activity and can unwind double-stranded RNA molecules with a 3' overhang (in vitro) (PubMed:25599396). [UniProt]
⚠WARNING: This product can expose you to chemicals including mercury, which is known to the State of California to cause birth defects or other reproductive harm. For more information go to www.P65Warnings.ca.gov.
仅用于科研。不用于诊断过程。未经明确授权不得转售。
篇参考文献 (0)
生物信息学
蛋白别名: aquarius homolog; IBP160; intron-binding protein aquarius; Intron-binding protein of 160 kDa; RNA helicase aquarius
基因别名: AQR; AW495846; KIAA0560; mKIAA0560
UniProt ID: (Mouse) Q8CFQ3
Entrez Gene ID: (Mouse) 11834, (Rat) 366163